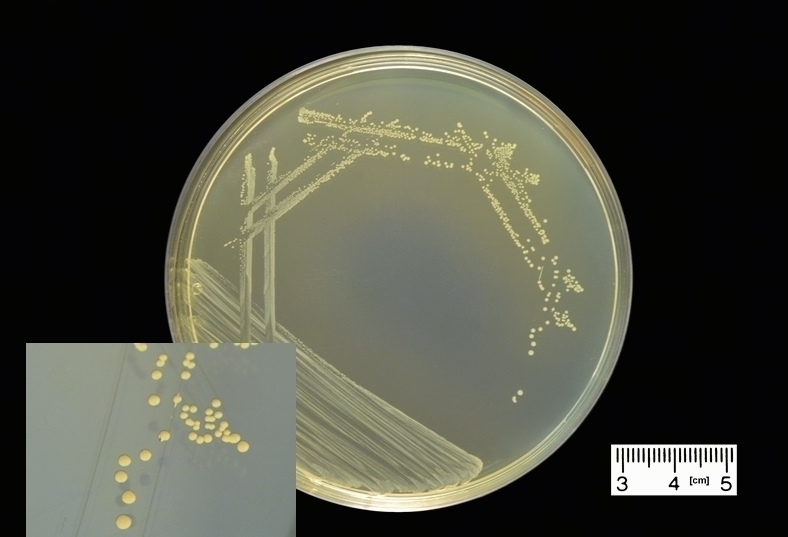

Enterococcus faecalis — бактерия, обитающая в кишечнике человека и играющая важную роль в микрофлоре. При определенных условиях она может стать патогенной и вызвать заболевания, особенно у мужчин. В статье рассмотрим, что такое Enterococcus faecalis, норму его содержания в мазках, моче и сперме, симптомы заболеваний, методы диагностики и подходы к лечению. Понимание этих аспектов поможет мужчинам своевременно выявлять и предотвращать осложнения, связанные с инфекциями, вызванными Enterococcus faecalis.
Инфекция enterococcus faecalis
Фекальный энтерококк (Enterococcus faecalis) представляет собой грамположительную условно-патогенную бактерию. В сочетании с другими микроорганизмами, такими как эшерихии, лактобактерии, бифидобактерии и бактероиды, он составляет часть нормальной микрофлоры кишечника человека и некоторых млекопитающих. В общей сложности таких бактерий насчитывается около 15 видов.
При определенных обстоятельствах фекальный энтерококк может стать патогенным и спровоцировать различные заболевания, затрагивая не только желудочно-кишечный тракт, но и уретру.
Врачи подчеркивают, что бактерия Enterococcus faecalis может представлять серьезную угрозу для здоровья мужчин, особенно в контексте инфекций мочевыводящих путей и половых органов. Эта бактерия, обычно обитающая в кишечнике, может вызывать воспалительные процессы, приводящие к циститу, простатиту и даже более серьезным осложнениям, таким как инфекции крови. У мужчин с ослабленным иммунитетом или хроническими заболеваниями риск развития тяжелых инфекций значительно возрастает. Кроме того, Enterococcus faecalis обладает способностью к антибиотикорезистентности, что затрудняет лечение и может привести к длительному течению болезни. Врачи настоятельно рекомендуют своевременно обращаться за медицинской помощью при появлении симптомов, таких как боль при мочеиспускании или дискомфорт в области таза, чтобы избежать серьезных последствий.
https://youtube.com/watch?v=7hYJ5AU0Rqs
Причины патологий
Одной из ключевых причин возникновения заболеваний, вызванных бактериями, является ослабление иммунной системы. Это может быть вызвано множеством факторов, включая частые простуды, наличие хронических заболеваний и длительное, неконтролируемое применение антибиотиков.
Медицинские препараты (лекарственные средства, витамины, биологически активные добавки) упоминаются исключительно для информационных целей. Мы настоятельно рекомендуем не использовать их без назначения врача. Рекомендуем ознакомиться с материалом: «Почему нельзя принимать лекарства без назначения врача?».
Фекальный энтерококк представляет собой микроорганизм, устойчивый к антибиотикам, что приводит к тому, что эти препараты уничтожают более слабые бактерии микрофлоры, способствуя его размножению и переходу из условно-патогенного состояния в патогенное.
На появление возбудителя в мочеполовой системе мужчин влияет несоблюдение правил личной гигиены. Если нательное белье не меняется чаще одного раза в два дня, не осуществляется мытье рук после туалета, а туалетная бумага используется неправильно, инфекция может попасть в уретру.
Лечение энтерококка в мужской мочеполовой системе представляет собой сложную задачу, поскольку в этом отделе мочеполового тракта находятся хламидии и микоплазмы, которые также являются условно-патогенными микроорганизмами. При ослаблении иммунной защиты и других неблагоприятных факторах они могут стать патогенными. В сочетании с фекальным энтерококком эти бактерии могут нанести значительный вред здоровью.
У детей этот микроорганизм является нормальным компонентом микрофлоры кишечника, мочеполового тракта и иногда ротовой полости. Переохлаждение, длительное и неконтролируемое применение антибиотиков, снижение иммунитета, а также несбалансированное и недостаточное питание могут привести к увеличению количества фекального энтерококка у ребенка и вызвать циститы, энтериты и колиты, а у девочек — вагиниты и вульвовагиниты.
Чем старше пациент, тем ниже вероятность перехода из условно-патогенного состояния в патогенное, поскольку важную роль в этом процессе играет постепенное развитие и усложнение работы иммунной системы.
| Аспект опасности | Описание | Возможные последствия |
|---|---|---|
| Инфекции мочевыводящих путей (ИМП) | Enterococcus faecalis является частой причиной ИМП у мужчин, особенно при наличии предрасполагающих факторов (например, увеличение простаты, катетеризация). | Цистит, уретрит, пиелонефрит, простатит. |
| Простатит | Бактерия может вызывать как острый, так и хронический простатит, что приводит к боли, дискомфорту и проблемам с мочеиспусканием. | Хроническая тазовая боль, эректильная дисфункция, бесплодие (в редких случаях). |
| Эпидидимит и орхит | Инфекция может распространяться на придаток яичка (эпидидимит) и само яичко (орхит), вызывая воспаление и боль. | Боль, отек, лихорадка, в редких случаях — бесплодие. |
| Бактериемия и сепсис | В тяжелых случаях бактерия может попасть в кровоток, вызывая бактериемию, которая может прогрессировать до сепсиса – опасного для жизни состояния. | Высокая температура, озноб, тахикардия, гипотония, полиорганная недостаточность, летальный исход. |
| Инфекции после операций | Enterococcus faecalis может вызывать инфекции после урологических операций (например, простатэктомии, цистоскопии). | Раневые инфекции, абсцессы, перитонит. |
| Формирование биопленок | Бактерия способна образовывать биопленки на медицинских устройствах (например, катетерах), что делает ее устойчивой к антибиотикам и иммунной системе. | Хронические, рецидивирующие инфекции, трудность в лечении. |
| Антибиотикорезистентность | Enterococcus faecalis часто проявляет устойчивость к широкому спектру антибиотиков, что затрудняет лечение инфекций. | Неэффективность стандартной антибиотикотерапии, необходимость использования более сильных и токсичных препаратов, увеличение продолжительности лечения. |
Симптомы заболеваний
К числу распространенных признаков воспалительного процесса, вызванного фекальным энтерококком, у мужчин можно отнести:
- Острая боль в паховой области и уретре (сопровождается ощущением рези и дискомфорта).
- Частые и болезненные позывы к мочеиспусканию и дефекации, зачастую с неприятным запахом.
- Изменение цвета мочи, ее помутнение.
- Появление гнойных выделений из уретры.
- Уменьшение полового влечения, затруднения с достижением оргазма и проблемы с эрекцией.
К общим симптомам заболевания относятся повышение температуры, головные боли, быстрая утомляемость и нарушения сна.
https://youtube.com/watch?v=rJOHT2OID3U
Лабораторные исследования
При возникновении первых признаков заболевания мужчине следует незамедлительно обратиться к врачу-урологу. Наибольшую угрозу представляет то, что фекальный энтерококк, размножаясь и оседая в уретре и простате, может со временем привести к эректильной дисфункции.
Для диагностики необходимо провести анализы кала, мочи и спермы.
Нормативные значения содержания бактерий в анализах:
- В мазке кала — от 10 в пятой до 10 в восьмой степени колониеобразующих единиц.
- В моче — 10 в пятой степени микробных тел на 1 мл мочи.
- В сперме — 10 в пятой степени микробных тел.
Анализ спермы
Для обнаружения enterococcus faecalis spp в сперме проводится посев на флору с определением чувствительности к широкому спектру антибиотиков. В качестве биоматериала используется эякулят.
В норме содержание enterococcus faecalis spp составляет 10 в пятой степени, однако даже уровень 10*4 может вызвать серьезные проблемы со здоровьем.
Таблица показателей спермограммы у мужчин, инфицированных бактерией:
| Показатель | Норма | Изменения при наличии бактерии |
| Enterococcus fecalis | Не более 10 в пятой степени | Увеличивается |
| Объем | 3-5 мл | Более 5 мл |
| рН | 7,2-7,8 | Повышается |
| Вязкость | 0,1-0,5 | Увеличивается |
| Количество сперматозоидов | 40-600 млн | Уменьшается |
| Цвет | Белый, сероватый | Не изменяется |
| Лейкоциты | 3-4 в поле зрения | Увеличивается |
| Живые сперматозоиды | Более 50% | Менее 50% |
| Слизь | Небольшое количество | Увеличивается |
| Эритроциты | Не содержится | Могут появляться |
https://youtube.com/watch?v=9q8iZLDFWvU
Лечение
Учитывая, что возбудителем является бактерия, наиболее эффективным способом лечения считается использование антибиотиков. В этом случае применяются антибактериальные средства широкого спектра, такие как Ципрофлоксацин, Ципролет, Левофлоксацин и Рифаксимин.
Избавиться от фекального энтерококка с помощью народных средств невозможно, так как для подавления его размножения требуются либо другие бактерии, либо антибиотики. При заболеваниях, требующих мочегонного эффекта, рекомендуется использовать настой петрушки, а овощи и фрукты помогут укрепить общее состояние организма. Также активно применяются пробиотики, содержащие лактозу и бифидобактерии, такие как Бифиформ, Лактиале, Биогайя и другие.
Если заболевание было обнаружено на ранних этапах, возможно применение Доксициклина. Обязательно следует использовать иммуномодуляторы для восстановления и поддержания естественного иммунитета организма.
При первых симптомах заболевания необходимо незамедлительно обратиться к врачу.
Источники
- Билимова С.И. Исследование факторов персистенции энтерококков. Журнал микробиологии. 2000, 4: 104, 105.
- Chenoweth C., Schaberg C. Эпидемиология энтерококков. Европейский журнал клинической микробиологии. 1990, 9: 80–89.
-
- Габриэлян И.Н., Горская Е.М., Спирина Т.С., Преображенская Т.Б. Энтерококки как патогены инфекционных послеоперационных осложнений. Журнал микробиологии. 2007, 4: 50–53.
- Balla E., Dicks L.M., du Toit M. и др. Характеризация и клонирование генов, кодирующих энтероцин 1071A и энтероцин 1071B, два антимикробных пептида, вырабатываемых Enterococcus faecalis BFE1071. Примененная и экологическая микробиология. 2000, 66: 1298–1304.
- Coque T.M., Patterson J.E., Steckelberg J.M. и др. Частота гемолизина, желатиназы и агрегатного вещества среди энтерококков, выделенных от пациентов с эндокардитом и другими инфекциями, а также из фекалий госпитализированных и амбулаторных пациентов. Журнал инфекционных заболеваний. 1995, 171 (5): 1223–1229.
- Fuller R. Пробиотики у человека и животных. Журнал прикладной бактериологии. 1989, 66: 365–378.
Профилактика инфекций
Эта бактерия, обитающая в кишечнике человека, может стать причиной различных инфекционных заболеваний, особенно при ослаблении иммунной системы или наличии других предрасполагающих факторов.
Одним из основных методов профилактики является соблюдение правил личной гигиены. Регулярное мытье рук, особенно после посещения туалета и перед приемом пищи, значительно снижает риск передачи инфекции. Также важно следить за чистотой половых органов, что особенно актуально для мужчин, так как Enterococcus faecalis может вызывать инфекции мочевыводящих путей и половых органов.
Кроме того, следует обратить внимание на рацион питания. Употребление достаточного количества пробиотиков, таких как йогурты и ферментированные продукты, может способствовать поддержанию здоровой микрофлоры кишечника, что, в свою очередь, помогает предотвратить избыточный рост патогенных бактерий, включая Enterococcus faecalis.
Важно также избегать незащищенных половых контактов, так как это может привести к передаче инфекции. Использование презервативов не только защищает от инфекций, передающихся половым путем, но и снижает риск заражения Enterococcus faecalis.
Регулярные медицинские осмотры и консультации с врачом помогут выявить возможные инфекции на ранних стадиях. Мужчинам, особенно с хроническими заболеваниями или ослабленным иммунитетом, рекомендуется проходить обследования на наличие инфекций, вызванных Enterococcus faecalis, чтобы своевременно начать лечение и избежать осложнений.
Наконец, важно помнить о вакцинации и укреплении иммунной системы. Здоровый образ жизни, включающий физическую активность, полноценный сон и отказ от вредных привычек, способствует повышению общей устойчивости организма к инфекциям.
Влияние на репродуктивное здоровье
Бактерия Enterococcus faecalis является частью нормальной микрофлоры кишечника человека, однако при определенных условиях она может стать патогенной и вызвать различные заболевания. У мужчин эта бактерия может оказывать негативное влияние на репродуктивное здоровье, что требует особого внимания.
Одним из основных аспектов, связанных с Enterococcus faecalis, является его способность вызывать инфекции мочевыводящих путей (ИМП). Эти инфекции могут проявляться в виде уретрита, цистита и простатита. Простатит, в частности, может быть вызван именно этой бактерией, что приводит к воспалению предстательной железы. Симптомы простатита включают боль в области таза, затрудненное мочеиспускание, а также снижение полового влечения и эректильную дисфункцию.
Кроме того, Enterococcus faecalis может быть связан с бесплодием у мужчин. Исследования показывают, что наличие этой бактерии в семенной жидкости может негативно сказываться на качестве спермы, снижая подвижность сперматозоидов и увеличивая количество аномальных форм. Это может затруднить процесс зачатия и привести к проблемам с репродуктивным здоровьем.
Важно отметить, что Enterococcus faecalis обладает высокой устойчивостью к антибиотикам, что делает лечение инфекций, вызванных этой бактерией, более сложным. В случае возникновения симптомов, связанных с инфекцией, важно обратиться к врачу для диагностики и назначения адекватной терапии. Самолечение может привести к ухудшению состояния и развитию хронических форм заболеваний.
Профилактика инфекций, связанных с Enterococcus faecalis, включает соблюдение правил личной гигиены, регулярные медицинские осмотры и поддержание здорового образа жизни. Мужчинам следует быть внимательными к своему здоровью и при первых признаках дискомфорта в области половых органов или мочевыводящих путей обращаться за медицинской помощью.
Резистентность к антибиотикам
Бактерия Enterococcus faecalis известна своей способностью вызывать различные инфекции у человека, и одной из наиболее тревожных характеристик этого микроорганизма является его высокая резистентность к антибиотикам. Эта резистентность делает лечение инфекций, вызванных Enterococcus faecalis, значительно более сложным и требует особого внимания со стороны медицинских специалистов.
Существует несколько механизмов, благодаря которым Enterococcus faecalis приобретает устойчивость к антибиотикам. Во-первых, эта бактерия обладает способностью обмениваться генами, отвечающими за резистентность, с другими микроорганизмами. Это означает, что даже если один штамм Enterococcus faecalis становится устойчивым к определенному антибиотику, он может передать этот ген другим бактериям, что приводит к распространению резистентности.
Во-вторых, Enterococcus faecalis может изменять свои клеточные стенки и метаболические пути, что позволяет ему избегать действия антибиотиков. Например, некоторые штаммы могут вырабатывать ферменты, которые разрушают антибиотики, или изменять свои рецепторы, чтобы антибиотики не могли связываться с клеточной стенкой.
Наиболее распространенными антибиотиками, к которым Enterococcus faecalis проявляет резистентность, являются пенициллины и ванкомицин. Ванкомицин, который считается «антибиотиком последней инстанции», часто используется для лечения тяжелых инфекций, вызванных устойчивыми к другим антибиотикам бактериями. Однако случаи резистентности к ванкомицину становятся все более частыми, что вызывает серьезные опасения в области общественного здравоохранения.
У Enterococcus faecalis не только затрудняет лечение инфекций, но и увеличивает риск осложнений, таких как сепсис, эндокардит и инфекции мочевыводящих путей. У мужчин, особенно тех, кто имеет ослабленный иммунитет или страдает от хронических заболеваний, такие инфекции могут иметь серьезные последствия.
В связи с растущей проблемой антибиотикорезистентности, важно проводить регулярные исследования и мониторинг штаммов Enterococcus faecalis, а также разрабатывать новые стратегии лечения и профилактики. Это включает в себя использование комбинаций антибиотиков, альтернативных методов лечения и более строгие меры по контролю инфекций в медицинских учреждениях.